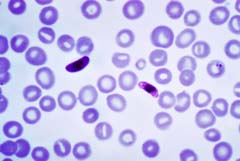

Theo hướng dẫn chẩn đoán và điều trị bệnh sốt rét do Bộ Y tế ban hành vào cuối năm 2009, tình trạng sốt rét tái phát, sốt rét tái nhiễm được xác định một cách cụ thể. Cần nhìn nhận đúng về vấn đề này để có biện pháp can thiệp phù hợp.
Đặc điểm của sốt rét tái phát
Sốt rét tái phát do nhiều nguyên nhân khác nhau như thể vô tính của ký sinh trùng sốt rét trong hồng cầu còn sót lại từ đợt trước tiếp tục phát triển, vượt ngưỡng gây sốt. Chủng loại ký sinh trùng Plasmodium falciparum, Plasmodium vivax thường có hiện tượng tái phát gần từ sau 7-14 ngày, còn được gọi là hiện tượng bột phát. Riêng loại Plasmodium falciparum có thể xuất hiện sau 3-6 tháng ở những người đã có một lần miễn dịch. Ngoài ra, chủng loại Plasmodium vivax, Plasmodium ovale có thể ngủ của ký sinh trùng ký sinh ở trong gan sẽ hoạt hóa phát triển và phóng thích các mảnh ký sinh trùng xâm nhập vào máu gây nên hiện tượng tái phát xa sau vài tuần hoặc sau 9-10 tháng. Đối với chủng loại Plamsodium malariae, một số trường hợp do chu kỳ vô tính tiềm tàng trong hồng cầu phát triển, hoạt hóa cũng gây nên sự tái phát.
Sốt rét tái phát thường xảy ra ở trên những bệnh nhân bị nhiễm ký sinh trùng Plasmodium falciparum kháng thuốc điều trị, thuốc sử dụng không diệt hết thể vô tính trong hồng cầu máu. Đối với bệnh nhân bị nhiễm Plasmodium vivax, không bảo đảm nguyên tắc sử dụng thuốc điều trị diệt thể ngủ trong gan kết hợp với thuốc điều trị cắt cơn sốt. Ngoài ra, những người trong tiền sử đã bị nhiễm ký sinh trùng sốt rét, tùy thuộc vào thời gian ký sinh trùng tồn tại trong cơ thể có thể có cơn sốt rét trước đó từ 1 - 2 năm khi bị nhiễm loại Plasmodium falciparum; từ 1,5 - 5 năm khi bị nhiễm loại Plasmodium vivax, Plasmodium ovale và từ 3 – 5 năm khi bị nhiễm loại Plasmodium malariae. Sốt rét tái phát thường gặp ở những người có hoàn cảnh lao động nặng nhọc và trong thời kỳ sơ nhiễm sốt rét ở 6 tháng đầu.
|  |
Plasmodium falciparum | Plasmodium vivax |
 |  |
Plasmodium ovale | Plasmodium malariae |
Đặc điểm của sốt rét tái nhiễm
Sốt rét tái nhiễm xảy ra ở những bệnh nhân đã từ lâu chỉ bị những cơn sốt nhẹ nhưng hiện nay cơn sốt xảy ra nặng liên tục nhiều ngày tương tự như cơn sốt rét sơ nhiễm. Mật độ ký sinh trùng thường cao, không thấy thể giao bào của ký sinh trùng ngay từ đầu được phát hiện cùng một lúc với thể tư dưỡng giống như trong cơn sốt rét tái phát. Sốt rét tái nhiễm thường gặp ở những người bệnh khi chuyển vùng và khi sống ở vùng sốt rét lưu hành nặng. Diễn biến bệnh cảnh lâm sàng thường nặng. Chẩn đoán xác định tương đối dễ nếu gặp những trường hợp bệnh nhân bị nhiễm chủng loại ký sinh trùng sốt rét khác với chủng loại bị nhiễm lần trước.
Sốt rét tái nhiễm thường xảy ra ở những người bệnh đã bị mắc sốt rét trước đó nhưng đã được điều trị tiệt căn, khỏi bệnh, nhiều năm liền không bị sốt rét tái phát; nếu bị sốt rét tái nhiễm thì bệnh nhân có bệnh cảnh lâm sàng giống như khi bị sốt rét sơ nhiễm lần đầu mặc dù chủng loại ký sinh trùng sốt rét bị nhiễm giống như chủng loại bị nhiễm trước kia.
Ở đây cũng cần nhắc đến trường hợp sốt rét sơ nhiễm để phân biệt với sốt rét tái nhiễm và sốt rét tái phát. Sốt rét sơ nhiễm xảy ra trên đối tượng người từ vùng không có sốt rét mới đến vùng có sốt rét lưu hành, chưa có miễn dịch với bệnh sốt rét và trẻ em từ 4 tháng tuổi đến 2 – 4 tuổi ở trong vùng sốt rét lưu hành. Căn cứ vào đặc điểm này để xác định các trường hợp bị mắc bệnh sốt rét có liên quan.
Xác định sốt rét tái phát và tái nhiễm để xử trí phù hợp
Theo hướng dẫn chẩn đoán và điều trị bệnh sốt rét đã được Bộ Y tế ban hành kèm theo Quyết định số 4605/QĐ-BYT ngày 24/11/2009. Khi điều trị bệnh nhân sốt rét cần bảo đảm, tuân thủ các nguyên tắc như điều trị sớm, đúng và đủ liều; phải điều trị cắt cơn sốt kết hợp với điều trị chống lây lan nếu bị nhiễm loại ký sinh trùng Plasmodium falciparum và điều trị tiệt căn nếu bị nhiễm loại ký sinh trùng Plasmodium vivax. Các trường hợp sốt rét do bị nhiễm Plasmodium falciparum không được dùng một loại thuốc sốt rét đơn thuần mà cần phải sử dụng thuốc điều trị phối hợp để hạn chế khả năng kháng thuốc của ký sinh trùng và tăng hiệu lực điều trị. Đồng thời ngoài việc điều trị bằng thuốc sốt rét đặc hiệu, nên kết hợp với việc điều trị hỗ trợ và nâng cao thể trạng của người bệnh.
 |  |
Biệt dược Arterakine | CV Artecan |
Đối diện với bệnh nhân sốt rét đã được chẩn đoán xác định, cần sử dụng thuốc điều trị ưu tiên (first line). Nếu bị mắc sốt rét do nhiễm Plasmodium falciparum cần điều trị thuốc phối hợp Dihydroartemisinine-Piperaquine (biệt dược Arterakine hoặc CV Artecan) 3 ngày kết hợp với Primaquine liều duy nhất vào ngày thứ tư. Nếu bị mắc sốt rét do nhiễm Plasmodium vivax cần điều trị thuốc Chloroquine 3 ngày kết hợp với Primaquine 14 ngày ngay từ ngày đầu khi dùng thuốc Chloroquine. Nếu bị mắc sốt rét do nhiễm Plasmodium malariae cần điều trị thuốc Chloroquine 3 ngày.
Các bác sĩ phải theo dõi bệnh nhân trong quá trình điều trị về mặt lâm sàng và ký sinh trùng để phát hiện và xử trí kịp thời các trường hợp sốt rét tái phát, sốt rét tái nhiễm. Nếu người bệnh xuất hiện trở lại ký sinh trùng trong vòng 14 ngày, được xem là sốt rét tái phát, phải điều trị thuốc điều trị thay thế (second line). Theo hướng dẫn của Bộ Y tế, thuốc điều trị thay thế được chỉ định dùng thuốc Quinine 7 ngày kết hợp với Doxycycline 7 ngày; đối với phũ nữ có thai và trẻ em dưới 8 tuổi dùng thuốc Quinine 7 ngày kết hợp với Clindamycine 7 ngày. Nếu người bệnh xuất hiện trở lại ký sinh trùng sau 14 ngày, được xem như sốt rét tái nhiễm và điều trị bằng thuốc điều trị ưu tiên (first line). Nếu gặp nhiều trường hợp điều trị thất bại đối với một loại thuốc tại cùng một cơ sở điều trị, cần báo cáo kịp thời lên tuyến trên để tiến hành xác minh ký sinh trùng sốt rét kháng thuốc.
Một vấn đề cũng cần chú ý khi theo dõi trong quá trình điều trị, nếu thấy người bệnh xuất hiện các dấu hiệu nguy hiểm như có rối loạn ý thức nhẹ thoáng qua với triệu chứng li bì, cuồng sảng, vật vã...; bị sốt cao liên tục, rối loạn tiêu hoá với triệu chứng nôn nhiều lần trong ngày, tiêu chảy mất nước, đau bụng cấp; bị nhức đầu dữ dội, thiếu máu nặng, da xanh, niêm mạc nhợt nhạt... trong vòng 3 ngày đầu điều trị và còn ký sinh trùng sốt rét thì phải điều trị khẩn cấp như điều trị sốt rét ác tính.
Ở trong vùng sốt rét lưu hành, một số trường hợp người bệnh có thể bị tình trạng sốt rét tái phát, rồi sốt rét tái nhiễm xảy ra các đợt tiếp nối nhau làm cho bệnh nhân có quan niệm rằng sốt rét là một bệnh mãn tính, kinh niên không thể điều trị khỏi. Thật ra, sốt rét là một bệnh có hạn định, dù không được điều trị và bệnh nhân có sức đề kháng tốt thì bệnh cũng có thể tự khỏi khi ký sinh trùng đã hết tuổi thọ ký sinh ở trong cơ thể với điều kiện không bị tái nhiễm lại. Muốn khắc phục hiện tượng sốt rét tái phát, phải bảo đảm đúng các nguyên tắc điều trị như đã nêu ở trên. Muốn khắc phục hiện tượng sốt rét tái nhiễm, cần thực hiện các biện pháp phòng bệnh có hiệu quả, hạn chế sự tiếp xúc của muỗi Anopheles mang mầm bệnh đốt máu và truyền bệnh. Ngủ màn thường xuyên khi đi vào vùng sốt rét lưu hành, ở trong vùng sốt rét hoặc lúc đi rừng, ngủ rẫy... là biện pháp tốt nhất để phòng bệnh.